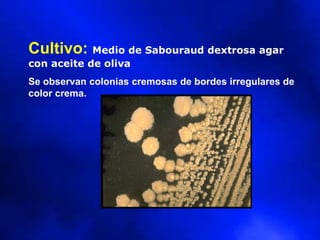
Cultivo: Medio de Sabouraud dextrosa agar
con aceite de oliva
Se observan colonias cremosas de bordes irregulares de
color crema.

Este documento describe los principales agentes causantes de las micosis superficiales, incluyendo hongos como Trichophyton, Microsporum y Epidermophyton. Discute varios tipos de micosis como queratomicosis, pilonodosis, candidiasis cutánea, dermatofitosis y onicomicosis. También describe las características clínicas, diagnóstico y tratamiento de varias afecciones micóticas como tiña de la cabeza, barba, cuerpo, ingle y pies.